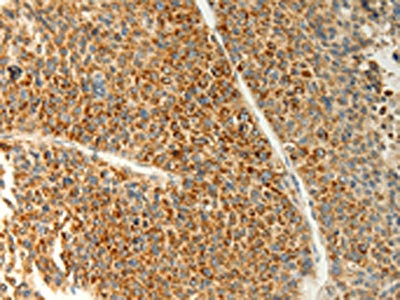

TRAF1 Antibody
-
中文名稱:TRAF1兔多克隆抗體
-
貨號:CSB-PA436548
-
規(guī)格:¥1100
-
圖片:
-
The image on the left is immunohistochemistry of paraffin-embedded Human liver cancer tissue using CSB-PA436548(TRAF1 Antibody) at dilution 1/20, on the right is treated with fusion protein. (Original magnification: ×200)
-
The image on the left is immunohistochemistry of paraffin-embedded Human colon cancer tissue using CSB-PA436548(TRAF1 Antibody) at dilution 1/20, on the right is treated with fusion protein. (Original magnification: ×200)
-
Gel: 10%SDS-PAGE, Lysate: 40 μg, Lane: Human lymphoma tissue, Primary antibody: CSB-PA436548(TRAF1 Antibody) at dilution 1/350, Secondary antibody: Goat anti rabbit IgG at 1/8000 dilution, Exposure time: 10 seconds
-
-
其他:
產(chǎn)品詳情
-
Uniprot No.:
-
基因名:
-
別名:4732496E14Rik antibody; EBI6 antibody; EBV induced protein 6 antibody; Epstein-Barr virus-induced protein 6 antibody; MGC:10353 antibody; Tnf receptor associated factor 1 antibody; TNF receptor-associated factor 1 antibody; TRAF 1 antibody; TRAF1 antibody; TRAF1_HUMAN antibody
-
宿主:Rabbit
-
反應(yīng)種屬:Human,Mouse
-
免疫原:Fusion protein of Human TRAF1
-
免疫原種屬:Homo sapiens (Human)
-
標記方式:Non-conjugated
-
抗體亞型:IgG
-
純化方式:Antigen affinity purification
-
濃度:It differs from different batches. Please contact us to confirm it.
-
保存緩沖液:-20°C, pH7.4 PBS, 0.05% NaN3, 40% Glycerol
-
產(chǎn)品提供形式:Liquid
-
應(yīng)用范圍:ELISA,WB,IHC
-
推薦稀釋比:
Application Recommended Dilution ELISA 1:1000-1:2000 WB 1:200-1:1000 IHC 1:25-1:100 -
Protocols:
-
儲存條件:Upon receipt, store at -20°C or -80°C. Avoid repeated freeze.
-
貨期:Basically, we can dispatch the products out in 1-3 working days after receiving your orders. Delivery time maybe differs from different purchasing way or location, please kindly consult your local distributors for specific delivery time.
-
用途:For Research Use Only. Not for use in diagnostic or therapeutic procedures.
相關(guān)產(chǎn)品
靶點詳情
-
功能:Adapter molecule that regulates the activation of NF-kappa-B and JNK. Plays a role in the regulation of cell survival and apoptosis. The heterotrimer formed by TRAF1 and TRAF2 is part of a E3 ubiquitin-protein ligase complex that promotes ubiquitination of target proteins, such as MAP3K14. The TRAF1/TRAF2 complex recruits the antiapoptotic E3 protein-ubiquitin ligases BIRC2 and BIRC3 to TNFRSF1B/TNFR2.
-
基因功能參考文獻:
- Results showed that TRAF1 was frequently upregulated in NSCLC tissues compared with adjacent non-cancerous lung tissues. TRAF1 expression was positively associated with NSCLC lymphatic metastasis and histological grade and was negatively associated with overall patient survival. PMID: 29528567
- TRAF1, CTGF, and CX3CL1 genes are hypomethylated in osteoarthritis PMID: 28470428
- Authors demonstrated that TRAF1 expression had no significant prognostic value for GBM. PMID: 28926524
- TRAF1 functions as a positive regulator of insulin resistance, inflammation, and hepatic steatosis dependent on the activation of ASK1-P38/JNK axis. PMID: 26860405
- The structure reveals both similarities and differences with other TRAF family members, which may be functionally relevant to TRAFs. The authors also found that the TRAF-N coiled-coil domain of TRAF1 is critical for the trimer formation and stability of the protein. PMID: 27151821
- this study reveals an unexpected role for TRAF1 in negatively regulating Toll-like receptor signaling, providing a mechanistic explanation for the increased inflammation seen with a rheumatoid arthritis-associated single-nucleotide polymorphism in the TRAF1 gene PMID: 27893701
- H. pylori infection significantly inhibits the cleavage of TRAF1 via a CagA-dependent mechanism, which would increase the relative amounts of full-length TRAF1 and exert an antiapoptotic effect on H. pylori-infected cells. PMID: 28082808
- Alleles of rs2416804 in TRAF1 were identified as being linked and associated with carotid intima-media thickness. PMID: 27827325
- Molecular basis for TANK recognition by TRAF1 revealed by the crystal structure of TRAF1/TANK complex has been reported. PMID: 28155233
- TRAF1 plays a crucial role in the pathogenesis of autoantibodies and may serve as a serologic inflammatory marker of disease activity in rheumatoid arthritis patients. PMID: 27592369
- Helicobacter pylori infection induces the overexpression of TRAF1 in gastric epithelial cells. The upregulation of TRAF1 plays an antiapoptotic role in Helicobacte pylori -infected gastric cells and may contribute to the gastric carcinogenesis. PMID: 27060717
- The increased serum TRAF-1 may be a useful non-invasive indicator of Renal cell carcinoma (RCC) development. PMID: 25158810
- Data suggest that, during B-cell transformation by Epstein-Barr virus, LMP1 (EBV latent membrane protein 1) induces signaling that stimulates Lys63-polyubiquitin chain attachment to TRAF1 (TNF receptor-associated factor 1) in the B-lymphocytes. PMID: 25996949
- This study did not replicate the association between PTPRC and the response to anti-TNF treatment in our Southern European population. We found that TRAF1/C5 risk RA variants potentially influence anti-TNF treatment response. PMID: 25834819
- Rs2900180 in C5-TRAF1 and linked variants in a 66Kb region were associated with radiographic progression in ACPA-negative RA PMID: 25566937
- TRAF1/C5 rs10818488 polymorphism is not a genetic risk factor for acquired aplastic anemia in a Chinese population. PMID: 25500258
- TRAF1-ALK translocation contributes to neoplastic phenotype in anaplastic large-cell lymphoma. PMID: 25533804
- DNMT3L can address DNMT3A/B to specific sites by directly interacting with TFs that do not directly interact with DNMT3A/B PMID: 24952347
- These findings suggest that the rs0818488 in TRAF1/C5 region is not associated with rheumatoid arthritis in Iranian population. PMID: 24338224
- genetic polymorphism is associated with rheumatoid arthritis susceptibility in Europeans Read More: http://informahealthcare.com/doi/full/10.3109/08820139.2013.837917 PMID: 24144456
- Genetic polymorphism rs10818488 in TRAF1/C5 gene might be associated with rheumatoid arthritis susceptibility. [Meta-analysis] PMID: 24234752
- Single nucleotide polymorphism of TRAF1 predicts the clinical response to anti-TNF treatment in Japanese patients with rheumatoid arthritis. PMID: 24321457
- The association between rs2900180 and rs3761847 polymorphisms and quality of life variables indicates that TRAF1 is involved in the induction of impaired quality of life in primary biliary cirrhosis. PMID: 23710202
- activation of TRAF-2 may be early events in the pathogenesis of inflammatory bowel disease PMID: 23414308
- TRAF1.NIK is a central complex linking canonical and non-canonical pathways by disrupting the TRAF2-cIAP2 ubiquitin ligase complex PMID: 23543740
- This represents the second independent study correlating rs2900180 at the TRAF1 locus with radiological severity in Rheumatoid Arthritis. PMID: 23242182
- The frequency of TRAF1 rs3761847 and rs2900180 polymorphisms did not differ between patients and controls. PMID: 23125866
- TRAF1 polymorphism is associated with systemic lupus erythematosus in North Africa group and rheumatoid arthritis in European population. PMID: 23321589
- An association was found between the rs10818488 polymorphism of TRAF1-C5 and susceptibility to systemic lupus erythemaosis in Europeans [Meta-analysis] PMID: 22820624
- We confirmed the positive association of rs10818488 A allele with rheimatoid arthritis in Tunisia. PMID: 22284611
- These findings identify TRAF1 as a potential biomarker of HIV-specific CD8 T cell fitness during the chronic phase of disease and a target for therapy. PMID: 22184633
- A genetic association of the TRAF1/C5, C1q, and eNOS gene polymorphism, but not of STAT4 and PTPN22, was found to confer a degree of risk for systemic lupus erythematosus in the Turkish population. PMID: 21968398
- TRAF1 polymorphisms contribute to rheumatoid arthritis susceptibility, activity, and severity in an Egyption population. PMID: 22196377
- Death domain SXXE/D motifs of TNFR1-death domain are phosphorylated, as is required for stable TNFR1-TRADD complex formation and subsequent activation of NF-kappaB in inflamed mucosa. PMID: 21724995
- Significant differences in SNPs rs3761847 and rs7021206 at TRAF1/C5 were observed between the case and control groups, the allelic p-value was 0.0018 with an odds ratio of 1.28 for rs3761847 and 0.005 with an odds ratio of 1.27 for rs7021206. PMID: 21492465
- 4-1BBL and TRAF1 in the CD8 T cell response to influenza virus and HIV PMID: 21153322
- Interaction of TRAF1 with I-kappa B kinase-2 and TRAF2 is important for regulation of NF-kappa B activity. PMID: 20856938
- results point to the involvement of the TRAF1/C5 locus in the aetiology of familial and severe alopecia areata (AA), and provide further support for a shared aetiology between AA and other autoimmune disorders. PMID: 20030635
- the human TRAF1 mRNA has an unusually long 5'-UTR that contains internal ribosome entry segment regulating its translation. PMID: 20413583
- Genetic markers in the 6q23 region and TRAF1-C5 are associated with rheumatoid arthritis, in particular with positive anti-cyclic citrullinated peptide and rheumatoid factor profile. PMID: 19401279
- crystal structures of the TRAF2: cIAP2 and the TRAF1: TRAF2: cIAP2 complexes; biochemical, structural, and cell biological studies on the interaction between TRAF2 and cIAP2 and on the ability of TRAF1 to modulate this interaction PMID: 20385093
- A significant association was found for the TRAF1-C5 locus in systemic lupus erythematosis, implying that this region lies in a pathway relevant to multiple autoimmune diseases. PMID: 19433411
- Results showed no influence of rs10818488 and rs2900180 TRAF1/C5 gene polymorphisms in susceptibility to and clinical expression of giant cell arteritis. PMID: 19918040
- Association of TRAF1-C5 locus with rheumatoid arthritis susceptibility was detected in the Japanese populations with modest magnitude, while no significant association was observed for systemic lupus erythematosus. PMID: 19336421
- Study of regulation of TRAF1, which was overexpressed in B-CLL lymphocytes, shows NF-kappaB/Rel activity in B-CLL nuclear extracts bind to TRAF1 promoter elements and regulation is IKK-independent. PMID: 12411322
- results suggest that tumor necrosis factor receptor-associated factor 1(TRAF1) exerts regulatory effects on receptor-induced nuclear factor-kappaB activation by targeting inhibitor of kappab kinase complex PMID: 12709429
- stoichiometry of TRAF1-TRAF2 heteromeric complexes ((TRAF2)2-TRAF1 versus TRAF2-(TRAF1)2) determines their capability to mediate CD40 signaling but has no major effect on TNF signaling PMID: 14557256
- Actinomycin D blocked PMA-mediated TRAF1 expression in colon cancer cells, suggesting induction at the transcriptional level. PMID: 14981539
- A constitutive expression of TRAF1, TRAF2, and TANK/I-TRAF in human gliomas was documented PMID: 16304992
- the t(11, 18)(q21;q21) translocation creating the c-IAP2.MALT1 fusion protein activates NF-kappaB independently of TRAF1 AND TRAF2 and contributes to human malignancy in the absence of signaling adaptors that might otherwise regulate its activity PMID: 16891304
顯示更多
收起更多
-
數(shù)據(jù)庫鏈接:
Most popular with customers
-
-
Phospho-YAP1 (S127) Recombinant Monoclonal Antibody
Applications: ELISA, WB, IHC
Species Reactivity: Human
-
-
-
-
-
-